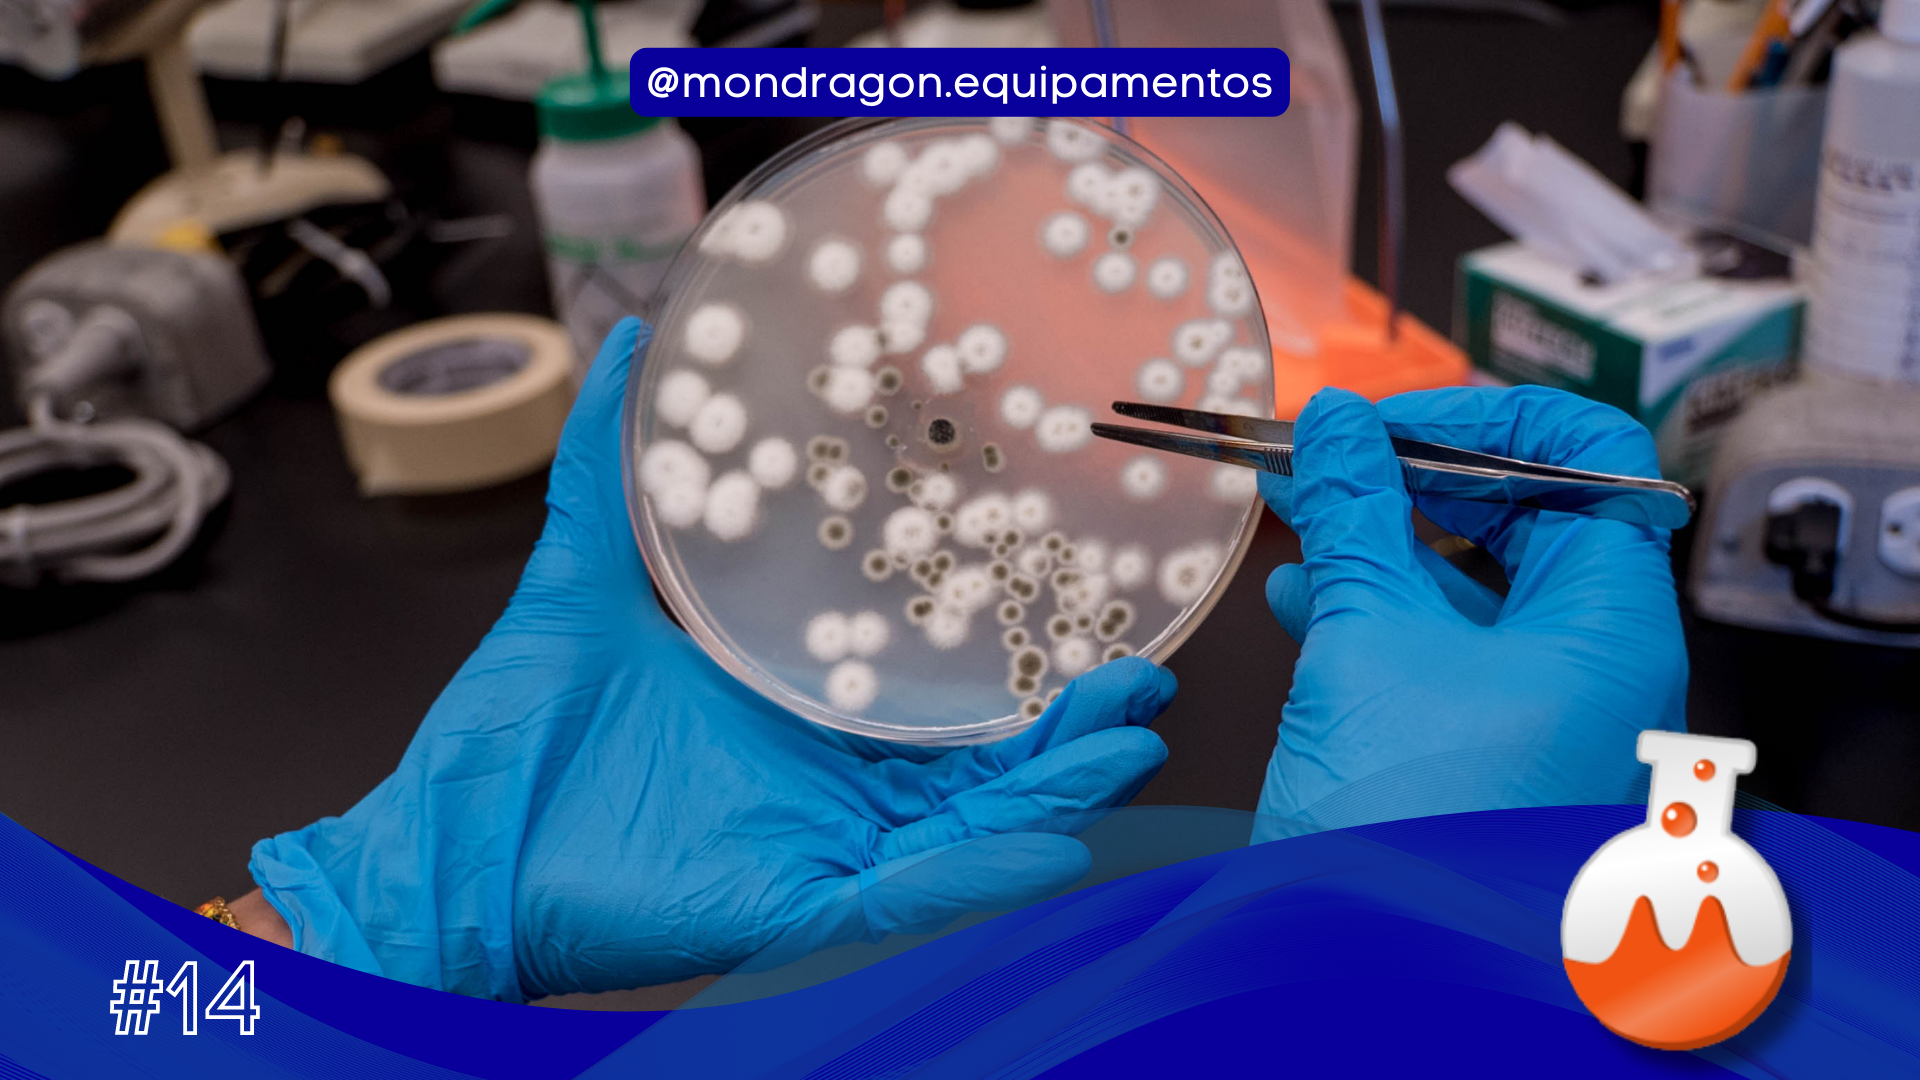

.
O setor de microbiologia é o responsável por vários fatores quando se fala em controle de segurança de três fatores: humano, máquina e ambiente, além disso a área de microbiologia pode estar em todas as etapas e ambientes de qualquer indústria, pois é ela que propicia um ambiente sanitário e limpo.
A Mondragon tem uma linha completa de equipamentos voltados para esse setor, hoje vou te dar um exemplo de linha de processo somente com equipamentos de microbiologia, vamos começar com a diluição da amostra, que pode ser feito com o Diluidor Gravimétrico, vamos seguir daí.
Após a diluição, os sacos contendo as amostras podem ser armazenados em porta-sacos, aguardando a homogeneização nos Homogeneizadores. Uma vez homogeneizado vamos para o Preparador Automático de Placas de Petri, que é usado para reduzir o número de placas processadas, oferecendo uma faixa de contagem de três vezes a diluição decimal em uma única placa. Após a incubação, as placas são automaticamente contadas contadas automaticamente com o nosso Contador de Colônias.
.
Gostou do nosso conteúdo? Acompanhe a Mondragon nas Redes Sociais e fique de olho nas nossas novidades e equipamentos! Ah, não esquece de curtir o post e comentar bastante, até a próxima 👋 @gidumkt